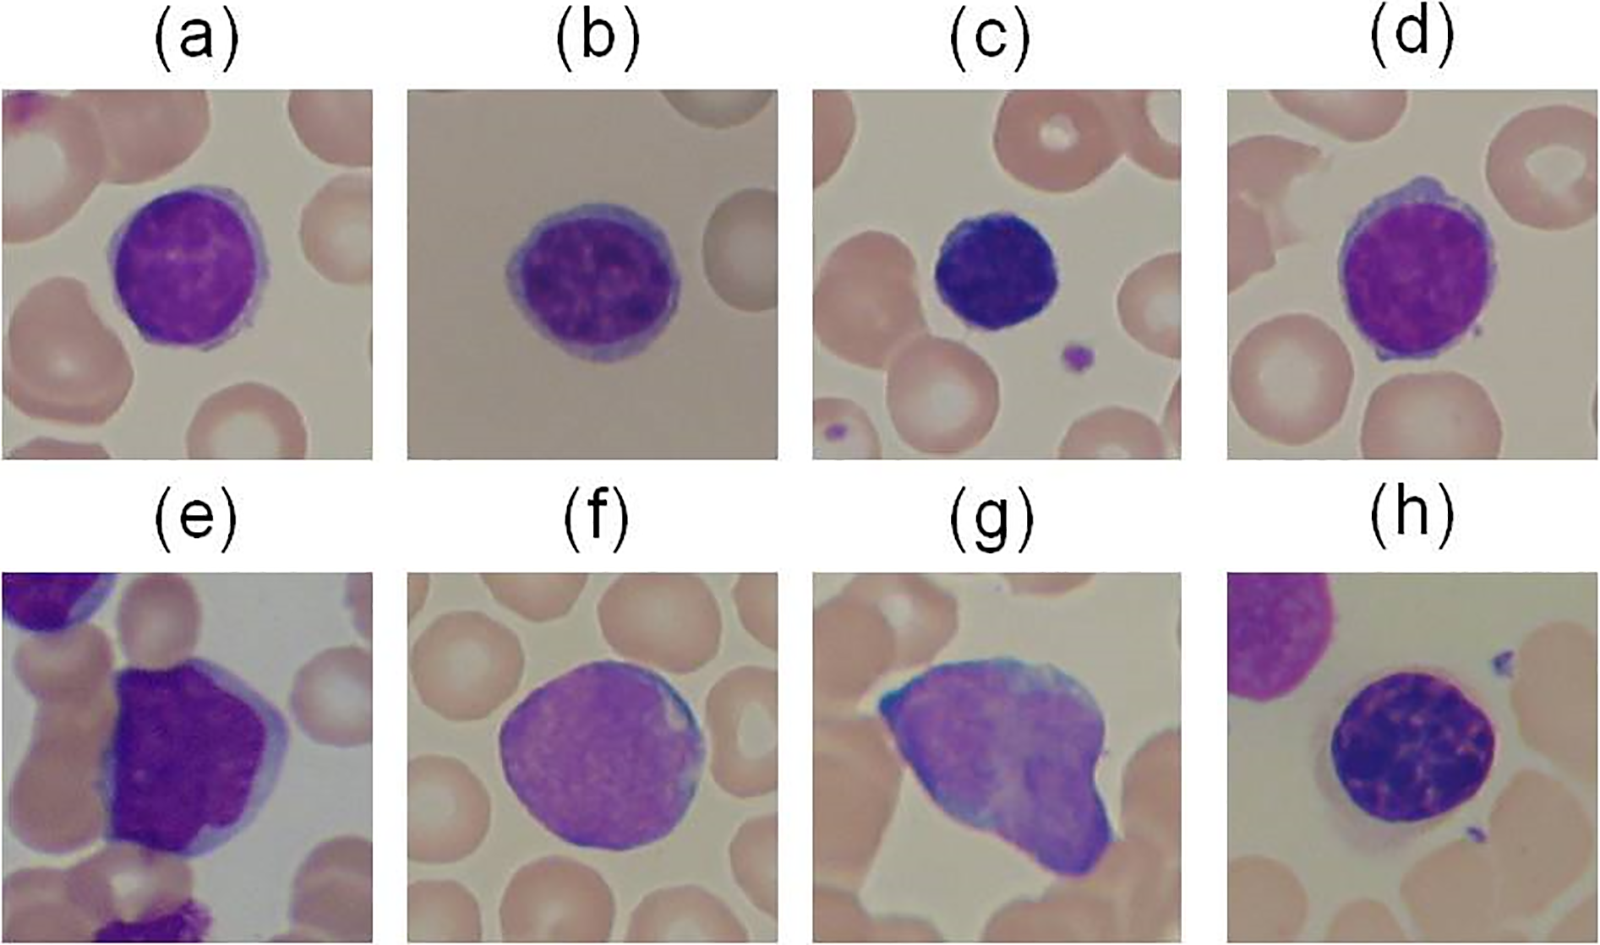
images

Open Access
REVIEW
Deep Learning and Artificial Intelligence-Driven Advanced Methods for Acute Lymphoblastic Leukemia Identification and Classification: A Systematic Review
1 Department of Computer Science, Islamia College, Peshawar, 25120, Pakistan
2 Department of Information Technology, The University of Haripur, Haripur, 22620, Pakistan
3 College of Technical Engineering, The Islamic University, Najaf, 100986, Iraq
4 School of Computing, Gachon University, Seongnam, 13120, Republic of Korea
5 Department of AI and Data Science, Sejong University, Seoul, 05006, Republic of Korea
* Corresponding Authors: Jawad Khan. Email: ; Yeong Hyeon Gu. Email:
(This article belongs to the Special Issue: Intelligent Medical Decision Support Systems: Methods and Applications)
Computer Modeling in Engineering & Sciences 2025, 142(2), 1199-1231. https://doi.org/10.32604/cmes.2025.057462
Received 18 August 2024; Accepted 20 December 2024; Issue published 27 January 2025
Abstract
Automatic detection of Leukemia or blood cancer is one of the most challenging tasks that need to be addressed in the healthcare system. Analysis of white blood cells (WBCs) in the blood or bone marrow microscopic slide images play a crucial part in early identification to facilitate medical experts. For Acute Lymphocytic Leukemia (ALL), the most preferred part of the blood or marrow is to be analyzed by the experts before it spreads in the whole body and the condition becomes worse. The researchers have done a lot of work in this field, to demonstrate a comprehensive analysis few literature reviews have been published focusing on various artificial intelligence-based techniques like machine and deep learning detection of ALL. The systematic review has been done in this article under the PRISMA guidelines which presents the most recent advancements in this field. Different image segmentation techniques were broadly studied and categorized from various online databases like Google Scholar, Science Direct, and PubMed as image processing-based, traditional machine and deep learning-based, and advanced deep learning-based models were presented. Convolutional Neural Networks (CNN) based on traditional models and then the recent advancements in CNN used for the classification of ALL into its subtypes. A critical analysis of the existing methods is provided to offer clarity on the current state of the field. Finally, the paper concludes with insights and suggestions for future research, aiming to guide new researchers in the development of advanced automated systems for detecting life-threatening diseases.Keywords
Medical image processing is an eminent field in machine learning and digital image processing. Doctors and healthcare companies face multiple problems in diagnosing cancerous cells in their very early stages [1]. If these diseases are not detected in their first stage, then it might result in the patient’s death. Leukemia is one of these diseases which directly assaults the body’s white blood cells, severely compromising the immune system [2]. In children, Acute Lymphocytic Leukemia (ALL) is perhaps the most frequent kind of leukemia; in adults, it is uncommon. As stated by the American Cancer Society in 2024, 6550 new cases were detected only in the United States and 1330 deaths occurred due to this life-threatening disease [3]. Based on their morphology, the FAB (French, American, British) are divided into three subtypes: L1, L2, and L3. The leukemic cells’ size, shape, and appearance under a microscope, together with their maturation traits, constitute the basis for these subtypes. L1, L2, and L3 as given in Figs. 1 and 2. L1 blasts have compact nucleoli with chromatin and regular nuclei, L2 has intensive basophilic structures with irregular nuclear shape and are large, and L3 blasts are large having cytoplasm with vacuoles in it. Among them, L1 and L2 are the common types while L3 is a rare type of ALL. To detect and classify these blasts, the researchers need to segment the region of interest, i.e., Cytoplasm and Nucleus. To understand the morphological structure of these cells the researcher must take assistance from medical Laboratory specialists and pathologists. Due to the complex nature of blasts, weak edges, inhomogeneity, noise, and overlapped cells examining these cells slides more difficult [4]. The three primary techniques used in the majority of automatic blood cell counting and analysis systems are feature extraction, segmentation, and classification of microscopic smear pictures. Digital processing aims to reduce human mistakes and associated costs. Different automatic and semi-automatic techniques were proposed in various research studies [5–7] proposed deep learning system, integrating DeepLabv3+ to segment and AlexNet for categorizing with high accuracy [8] uses k-means algorithm [9] used morphological operations [10] proposed morphological operation with top-hat transforms [11] suggested transfer learning with convolution neural networks (CNN) [12] uses textural, shape and spectral features with support vector machine (SVM) [13] uses k-means with SVM [14] different thresholding and region based algorithms [15] discussed different deep learning algorithms [16] cluster of differentiation CD markav for leukemia detection [17,18] k-means clustering, [19] artificial intelligence-based machine and deep learning techniques were applied [20]. Still, recent advancements in AI can help propose state-of-the-art techniques for detecting these hematology study’s datasets due to the lack of available and comparing the existing methods. Bone marrow and blood smear slide images are the main source for the dataset of this study due to the lack of availability of datasets. In this study, a review of different techniques has been done in our paper, using methods from machine learning, deep learning, and image processing.

Figure 1: Acute Lymphoblastic Leukemia and its subtypes

Figure 2: Pictorial representation of ALL subtypes and Reactive bone marrow slide images: (a) L1; (b) L2; (c) L3; and (d) Normal
The four questions have been framed using the PICO (Patient, Intervention, Comparison, and Outcome) paradigm, which serves as the foundation for several topics relevant to the main focus of the study:
1. What methods are available for the automatic identification and categorization of acute lymphoblastic leukemia?
2. Which technique achieves maximum accuracy in terms of ALL detection and classification?
3. What kind of datasets have been used for the required tasks?
4. What are the issues that are confronted during the detection of ALL?
Section 2 of this paper consists of a review of the literature on current techniques; in Section 3 research issues have been mentioned and Section 4 is the conclusion of this review study.
Acute lymphoblastic leukemia (ALL) is an extremely severe hematological cancer necessitating accurate detection and classification for optimal treatment. Conventional diagnostic techniques, however effective, may encounter constraints in precision and efficacy. Recent breakthroughs in machine learning (ML) and deep learning (DL) technology present interesting possibilities for improving diagnostic procedures. The incorporation, of these computational methods into clinical practice is inconsistent, exhibiting disparities in the performance of models, quality of data, and interpretability among research. This systematic review evaluates the landscape of machine learning and deep learning methodologies for detecting and classifying ALL. It will assess the efficacy, resilience, and therapeutic relevance of these procedures in comparison [21,22] and [23], to traditional methods. The review will also pinpoint current problems, including data diversity, validating models, and the necessity for explainable AI in healthcare environments. This study aims to emphasize the potential of machine learning and deep learning in enhancing diagnostic precision and effectiveness in acute lymphoblastic leukemia, thereby informing future studies and clinical applications in hematology.
An important part of this research effort is the identification of blasts, which is made possible by the segmentation of the cytoplasm and nucleus in the slide image. We mention the pre-existing segmentation techniques for this work. Following segmentation, Classifying the region of interest requires a range of deep learning and traditional machine learning techniques [24]. This systematic review is carried out by PRISMA guidelines [25]. PRISMA, which is mostly focused on presenting evaluations that analyze the impact of actions, is a minimal set of reporting criteria for systemic reviews and meta-analyses that are supported by evidence [23]. From 01 October to 20 February 2024, a comprehensive search was carried out on three distinct online databases. Google Scholar, PubMed, and Science Direct to find the pertinent documents. These are free web indexes that provide full text or information for academic works in a variety of distributed arrangements. Users of Science Direct can access Elsevier’s vast bibliographic database of scientific and healthcare publications. During this search different keywords have been searched, i.e., (Acute Lymphoblastic Leukemia using Deep Learning), (Bone Marrow and Blood Smear), (Traditional Machine Learning), (Detection of ALL). As shown in Table 1, the grounds for inclusion and removal are used to identify papers. The collected publications are screened using the Prisma flowchart shown in Fig. 3. According to the aforementioned research, 1413 have been identified in total. 513 articles chosen for the second screening round following the publishing of similar publications and papers before 2005 were removed in the first screening. In the second phase, articles were reviewed and publications were removed by the criteria listed in Table 1. Based on full-text reading, the eligibility of 93 articles was assessed. Additionally, 07 articles that examined various blood disorders including multiple disqualified due to their lack of results in the text. Following that, a final shortlist was created after reading the entire paper. 84 articles are included in the systematic review based on the inclusion criteria. Just peer-reviewed research articles, incorporating clinical trials, qualitative studies, and meta-analyses, that concentrate on the detection and classification of ALL, or acute lymphoblastic leukemia, utilizing ML and DL methodologies were included [26]. Convention abstracts and unpublished research were omitted to ensure rigor. Research must explicitly focus on the implementation of machine learning or deep learning techniques within the framework of ALL. This encompasses any research that assesses model performance criteria (e.g., precision, sensitivity, specificity) in the detection and classification of all subtypes. When analyzing papers on ALL from multiple online databases, it is critical to consider potential biases in literature selection that may influence the findings. Publication bias, for example, may cause an overrepresentation of research with favorable or significant outcomes, possibly distorting views of treatment efficacy. Language bias might further restrict the scope of studies considered, as non-English publications may be disregarded [22]. Furthermore, separate databases may index different journals or study categories, thus leading to an imbalance in the presentation of randomized controlled experiments vs observational studies. Selective reporting of primarily positive outcomes, as well as time lag bias, in which newer negative or null results are revealed later, can skew our overall picture of ALL treatments. Geographic biases, with additional research from high-income nations dominating the literature, may limit the findings’ applicability to different populations. To address these challenges, researchers must accept their biases, disclose the limits of the included studies, and strive for comprehensive, comprehensive reviews that include a diverse variety of study types and demographics [23].


Figure 3: Scenario of inclusion and exclusion of articles in a systematic review
The selection of effective segmentation techniques is important in distinguishing the area of interest [26]. The segmented images are shown in Fig. 4 and deep learning-based segmentation framework is shown in Fig. 5. The literature different segmentation algorithms were used to achieve the goal.

Figure 4: Segmented images of ALL

Figure 5: Framework for segmentation of the region of interest in ALL Using Deep Learning
2.1.1 Segmentation Using Thresholding Method
Authors in [26] used the Hue saturation values (HSV)color model and segmentation method with Otsu thresholding applied to the S component and considered shape feature for detection, based on thresholding for the detection of ALL blasts. Abbas et al. [27] applied a convolution with a 2*2/6 mask on RGB and then used the Otsu method to segment nuclei after this noise was removed and the region of interest was dilated to achieve the best results. Another study [28] presented a method based on edge detection and the Gradient Vector Flow (GVF) model for the segmentation of ALL blasts but using Zack thresholding to segment the cytoplasm of the cell. Ur Rahman et al. [29] came up with a segmentation-based threshold method, The image is processed after initially being converted to HSV color space. Only the S part by converted to binary then the high threshold value is selected, and the low is removed after this the image is converted back to RGB. Authors in [30] present a method for complete blood count, in their study WBCs and Red blood cells (RBCs)were extracted with thresholding and Otsu’s method. The cell counting is based on topological structure analysis and predicted mass region of the cells through Hough Circle Transform (HCT) with an accuracy of 100% and 92.93%, respectively. Scotti [31] proposed a framework that segments WBC using the gray-level threshold method. Rezatofighi et al. [32] used the Gram-Schmidt technique for the segmentation of nuclei and also applied thresholding to correctly segment cytoplasm. In another study [33], they upgraded the system using the Gram-Schmidt method with the orthogonality principle with the desired color vector for identification of the nucleus with an accurate threshold. Deshpande et al. [34] came up with a method that relies on the Otsu threshold method for the detection of leukocytes using the ALL-IDB dataset. In the study, Hazlyna et al. [35] used threshold values using the HIS color model to separate blasts from the background region. Authors in [36] presented a segmentation method for the conversion of contrast images into binary using the Otsu thresholding method with 80.6% accuracy. Authors in [37] used fuzzy set thresholding for effective segmentation. In a research work by Ahasan et al. [38] segmentation algorithm for nuclei of leukocytes using morphological operations associated with color and Otsu thresholding, filters, and watershed markers for removing borders with 88.57% accuracy. Lina et al. [39] proposed color filtering with a threshold value for the detection of leukocytes with an accuracy of 82.12%. Di Ruberto et al. [40] proposed a new scheme based on a triangle threshold to segment nuclei with cytoplasm in leukocytes. Gosh et al. [41] come up with a system for identifying leukemia which is in light of adaptive thresholding and fuzzy deviation. Li et al. [42] proposed a segmentation method for ALL based on a dual threshold and attained 97.85% accuracy. Abbas et al. [43] presented a threshold-based segmentation scheme and improved the accuracy by 0.8955%.
2.1.2 Segmentation Using Watershed Transform
A research work by Jiang et al. [44] came up, with segmentation using the watershed clustering method for the separation, of cytoplasm in WBCs. Ghane et al. [45] came up, with a new framework composed of watershed transform, k-means clustering, and thresholding methods for the segmentation, of leukocytes and their nucleus. Authors in research work [46] proposed a framework to segment lymphocytes by using watershed transform and average shift clustering.
2.1.3 Segmentation with K-Means Clustering
Study [47] proposed a system for the identification, of ALL using a clustering algorithm followed by Simulating Discernment Measure which can segment lymphoblasts and lymphocytes and then classify them using a multi-level perceptron and Support Vector Machine (SVM). In study [48], Agaian with others presented a framework to identify ALL by using k-means clustering to divide the blast nuclei. Sajjad et al. [48] came up with a method that segments the WBC nucleus using k-means. In another study, the authors [49] Su et al. gave a computerized framework for decision-making in the medical field that identifies hematological disorders in human blood using a clustering algorithm. Reference [50] used k-means clustering to count blasts and normal cells for Acute Myeloid Leukemia (AML). Moradiamin et al. [51] suggested a strategy for splitting lymphoblasts using k-means clustering algorithms. Authors in [52] also used k nearest neighbor for medical diagnostics.
2.1.4 Segmentation Based on Region Growing Algorithm
Gómez et al. [53] presented a seeded region growing algorithm for the detection of cells giving good results. In another study, Hazwani et al. [54] gave a framework to detect AML and ALL blasts. The S component that has been processed of the HSI color space to retrieve threshold value using region growing to segment the interested part. Madhloom et al. [55] presented a segmentation method in light of morphological operation and region growth with histogram equalization for blasts, it results in an accuracy of 96% for blasts and 94% for cytoplasm and nucleus.
2.1.5 Other Morphological Operations and Algorithms
Authors in [56] proposed a framework for the segmentation of nuclei and cytoplasm with shapes and active contours followed by a vector flow model. Theera-Umpon et al. [57] presented a system that can segment WBC and is based on mathematical morphology. After segmentation, Bayes’s classifier with neural networks is used fivefold and results in 77% accuracy. In [58], Piuri et al. worked on the automatic detection of leukocyte color images. Leukocytes were separated from other cells in blood slides with morphological operations and used neural network for classification of WBCs into its subtypes. In paper [59], Scotti used morphological operations that separate leukocytes from other blood components in the slide. Vogado et al. [60] employed morphological operations to divide leukemic cells into segments using the ALL-IDB2 dataset. Bhattacharjee et al. [61] used morphological operations to separate the nucleus, k-mean clustering ANN, and SVM. Grimwade et al. [62] came up with flow cytometry to identify acute leukemia using morphological methods. Bhukaya et al. [63] presented a framework for separating nuclei and leukocytes using Otsu thresholding and morphological operation to detect ALL, SVM has a 92.7% classification accuracy rate. In another study [64], authors used a watershed algorithm followed by thresholding and morphological operations to segment blasts for categorization in acute leukemia. The authors of this study [65] came up with morphological methods with scale-space features for the accurate segmenting of leukocytes. There are two stages to the suggested strategy. White blood cells (WBCs) are collected from the microscopic blood picture during the first stage. Important information, like shape and texture features, is extracted from the segmented cells in the second step. In the end, the segmented cells are divided into normal and abnormal cells using Naïve Bayes and k-nearest neighbor classifier approaches applied to the retrieved features resulting in 98.7% accuracy [66]. Authors in [67] proposed a step method for segmentation and classification of ALL using the ALL-IDB dataset to classify normal and abnormal cells. A summary of some of the important techniques for ALL diagnoses is listed in Table 2.
2.1.6 Limitations of Traditional ML Techniques
Conventional machine learning techniques exhibit numerous limitations, particularly in their inability to effectively model complicated, non-linear relationships within data, hence impairing performance on sophisticated tasks. They often demand comprehensive feature engineering, requiring substantial subject knowledge and effort involvement. Moreover, these models may exhibit sensitivity to noise and outliers, which can result in false predictions. They may not perform efficiently with extensive datasets, where more sophisticated algorithms thrive. Ultimately, once trained, conventional models generally exhibit little sensitivity to new data without undergoing retraining, rendering them less efficient in dynamic contexts.
2.1.7 Segmentation Using Deep Learning Techniques
Image segmentation is one of the most important problems, particularly in the medical field, the researchers preferred to use more advanced deep-learning models [69–71] to address this problem, as the framework is shown in Fig. 5. Wang et al. [72] proposed a technique based on Convolutional Neural Networks (CNN) and a single-shot multi-box detector [73] and modified YOLOv3 for the detection of WBC. Mandal et al. [74] and Shahin et al. suggested a deep learning model, a U-Net-based semantic model, that can find overlapping nuclei. Reference [75] proposed a transfer-learning-based approach that can segment WBC and its subtypes, and they proposed a customized CNN model (WBCsNet) with more accurate results [76]. Duggal, Rahul, et al. [77] used deep belief networks to segment WBC nuclei more accurately. Reena and Ameer [78] proposed a segmentation method based on transfer learning for WBCs, for semantic segmentation they used DeepLabV3+.
When considering an image segmentation technique for cancer cell images, it is essential to comprehend the advantages and disadvantages of each method. Otsu thresholding is most applicable to images exhibiting pronounced intensity peaks, providing a straightforward and efficient method, however, it has difficulties in noisy or intricate backgrounds [30]. K-means clustering is proficient in managing diverse cell kinds and fluctuating intensities, rendering it versatile however susceptible to initial conditions and the number of clusters. Region growing is optimal for segmenting contiguous areas based on intensity, effectively accommodating intricate shapes, however necessitating, a meticulous selection of seed sites and criteria [57]. The decision ultimately hinges on the particular image attributes and segmentation objectives, and frequently, a synthesis of several methodologies may produce optimal outcomes.
Efficient segmentation methods markedly improve the diagnosis of acute lymphoblastic leukemia (ALL) by precisely delineating areas of interest in medical imaging, including bone marrow biopsies and blood smears. This procedure enhances classification precision by diminishing background noise, accentuating essential cellular characteristics, and standardizing diversity among patient presentations [79]. Segmentation improves feature extraction and enables multimodal analysis by supplying cleaner, more pertinent data, enhancing the integration of images, genomic, and clinical information. Moreover, sophisticated methods for segmentation automate processing, enhancing efficiency and facilitating continuous evaluation of treatment responses. Ultimately, these advantages improve diagnostic precision and refine clinical decision-making in ALL management [80]. U-Net is a convolutional neural network (CNN) architecture specifically developed for image segmentation tasks, aiming to categorize each pixel within an image [81]. Initially created for biological image segmentation as shown in Fig. 5, it has been extensively utilized across other domains. The network employs an encoder-decoder architecture. The encoder, or contracting path, systematically reduces the input image’s dimensions using convolutional layers and pooling processes, capturing contextual information and retrieving high-level features [82]. The decoder, or expanding path, subsequently upsamples these feature maps, progressively rebuilding the spatial dimensions of the image while preserving detailed information. The distinguishing characteristic of U-Net compared to other segmentation models is the implementation of skip connections, which connect appropriate layers in the encoder and decoder, enabling the model to integrate low-level, detailed information with high-level relevant attributes [83]. This architecture allows U-Net to generate precise and intricate segmentations, even when trained on comparatively limited datasets. Its efficacy and performance have rendered it particularly favored in medical imaging, where accurate segmentation is essential.
2.2 Image Classification Using Traditional Machine Learning
Ko et al. [82] proposed a method for the classification of WBC using random forests and decision trees with effective results. Ramoser et al. [83] came up with a technique for the identification and classification of lymphocytes using an SVM into its subtype, [84,85]. Tai et al. [86] suggested a method that is used to segment and classify various components in blood slide images to separate the nucleus and cytoplasm. Geometric features with multi-class SVM are used to classify them. Mohapatra et al. [87] used features like the Hausdroff Dimension with contour signature to detect nuclei boundaries and then classify them using SVM. Studies [88,89], Rawat et al. outlined a system to distinguish between normal and ALL leukocytes using Gray-level Co-occurrence matrix GLCM and shape features, SVM, and random forest for classification respectively. It gives 86.7% accuracy for nuclei, 72.4% for cytoplasm, and overall accuracy of 89.8%. MoradiAmin et al. [90] gives a framework that can categorize leukemia into its four types using SVM. Pan with others in [91] used the mean shift technique for the partition of the nucleus of WBCs, using the learning-by-training method SVM. Mohapatra et al. [92] came up with a color-based clustering technique using k-means and Fuzzy Possibilistic C-means in combination with Gustafson Kessel for the segmentation nuclei from white blood cells to identify ALL Blasts using the SVM classifier. James et al. [93] segment WBC to use the k-means clustering approach to find AML, normal, and cancerous cells were classified using SVM. Asadi et al. [94] used a holographic method for the detection and categorization of leukemic cells using Zernike moments for feature extraction and then classified the cells with k-nearest neighbor (KNN) using minimum mean distance. Authors in [95,96] proposed a method that identifies ALL using CMYK color format and then the Zack threshold method, classified the cells using KNN, and gives good accuracy. Di Ruberto with others in [97] came up with a framework consisting of the combination of KNN and SVM that can segment and classify different components of blood and their nucleus and cytoplasm, resulting in an accuracy of 99% using the ALL-IDB data set.
2.3 Classification Using Deep Learning Techniques
Sahlol et al.’s research [98] presented a framework based on CNN with a visual geometry group (VGG) net model. They enhanced the slap swarm algorithm statistically to classify the subtypes of leukocytes. Rehman et al. [99] segmented the ALL blasts using the threshold method and then used the CNN-based Alexnet model which gives efficient results and gives 97.78% accuracy. Shafique et al. [100] suggested a framework composed of CNN with an Alexnet model for identifying ALL using the ALL(IDB) database and gave the result of 96.06% accuracy. Loey et al. [101] proposed a model for the diagnosis of ALL, CNN with Alexnet model is used on the ALL (IDB) database and classifies images into two classes, i.e., normal and affected giving 100% results. Mallick PK with others in [102] came up with a framework based on Deep Neural Network (DNN) through which they classify two classes, i.e., ALL and AML, and resulted in 98.2% accuracy. In [103], the research work develops a diagnosis and detection of ALL that enhances different blood images with adaptive sharpening and then uses deep learning techniques [104]. A thorough overview of the deep learning architectures in Fig. 6, including model architecture, training procedure, and hyperparameter values, is required to comprehend and replicate the work fully. This includes a comprehensive description of the model’s general architecture as shown in Fig. 6, including the very first step of dataset collection and pre-processing of that data, after this the segmentation algorithms are selected and the region of interest is segmented as shown in Fig. 5 after this step robust classification technique is selected and layout of layers are set according to the need of the required results (e.g., convolution, recurrent, fully connected), functions for activation, and any other relevant components. The training method is thoroughly detailed, including information about the datasets utilized, the number of epochs, batch sizes, and the optimization techniques (such as Adam or Stochastic gradient descent (SGD)) used to achieve the best results [105]. Furthermore, hyperparameter settings should be properly specified, such as learning rates, dropout rates, weight initialization methods, and regularization approaches. Providing these facts encourages transparency, enabling others to duplicate the study and evaluate the effectiveness of the model under identical conditions, which is critical for scientific accuracy and field advancement [103].

Figure 6: Deep learning based ALL classification framework
2.4 Convolution Neural Network Architecture
A Convolutional Neural Network (CNN) architecture can be built with many essential components and hyperparameters that influence the model’s functionality. This article provides a summary of the standard layers and parameters utilized in the construction of a CNN, together with their traditional values [105].
The input to a CNN typically consists of an image, with dimensions represented as (Height, Width, and Channels). For RGB images, the input dimension is (224, 224, 3), where 224 × 224 represents the image size and 3 denotes the total number of color components (Red, Green, Blue).
Convolutional layers apply filters to the input image or the output of the preceding layer to extract features. The quantity of convolutional filters that the next layer will acquire. Standard values vary from 16 to 512 filters in each layer. The dimensions of these filters are often (3 × 3), (5 × 5), or (7 × 7). Smaller filters, such as 3 × 3, are prevalent in deeper designs. The filter’s step size during the input image scanning process. A stride of one or two is typical. Finds out the need for padding the input to maintain spatial dimensions [106].
An activation function is performed post-convolution to introduce non-linearity. The Rectified Linear Unit (ReLU) is the predominant activation function. Alternative activation functions such as Leaky ReLU or ELU may be employed in certain architectures.
Pooling layers diminish the spatial features of the input, hence reducing the computational burden and facilitating the extraction of salient information. Max Pooling: Generally, employs a (2 × 2) or (3 × 3) filtration with a stride of 2. Average pooling computes the mean of values within a pooling window; nevertheless, max pooling has been more usually utilized [106].
These layers are employed after the convolutional and pooling layers to provide predictions or classify features. The number of neurons in each fully connected layer. The number of neurons in the initial completely linked layer can fluctuate, often ranging from 512 to 1024. Activation Function: Generally, ReLU is employed for hidden layers, whereas Softmax or Sigmoid is utilized for the output layer, depending on whether the objective is multi-class or binary classification, respectively [103].
Hyperparameters: Learning Rate: Regulates the magnitude of weight adjustments during training. A conventional initial value is 0.001, however, it is frequently adjusted throughout the training process. Optimizers such as Adam, SGD, or RMSprop are frequently employed. Adam is generally the preferred option because of its flexible learning rate. Batch Size: The quantity of samples handled in a single iteration through the network. Standard values vary from 32 to 128. Epochs: The total count of full iterations over the complete training dataset. Typical values span from 10 to 100.
In recent years, different CNN models have been used to those results in more accurate and efficient ways [107] as given in Table 3. Graphical representations of different machine and deep learning techniques were given in Fig. 7. YOLOv3 [108] and YOLOv4 [109] are some of the recent faster CNN models, these are models with high computational efficiency for localizing the region of interest and classification tasks. Ai-Qudah et al. [110] used YOLOv2 [111] to classify ALL into normal/healthy cells efficiently. Khandekar et al. [112] suggested a classification technique based on YOLOv4, classifying healthy and ALL-blasts efficiently. Authors in [50] also proposed medical robotic diagnosis based on deep learning methods. Duggal et al. [113] suggested CNN CNN-based framework for cancer detection with a deconvolution layer that can convert the images to Optical Density. It also involves back-propagation to de-convolve the images to tissue-specific for the next layer as input. The authors suggested a unique technique based on the examination of the available white blood cells (WBC) to identify acute lymphoblastic leukemia (ALL) in the blood’s peripheral circulation. In contrast to previous approaches described in the literature, this technique combines a histopathological transfer learning process with a lightweight CNN. This is achieved by introducing a CNN with less learnable parameters that mimic Local Binary Patterns (LBP) and learning to recognize different types of histology tissues. It then fine-tunes this CNN on the ALL database to categorize each cell as either normal or lymphoblast. Sulaiman et al. [114] suggested a hybrid model with an accuracy claim of an F1 score of 0.929 for the classification of ALL into healthy and infect groups, based on ResNet and SVM. Reference [115] suggested the automated identification of healthy cells and ALL to compensate for the manual analysis deficiencies of an expert. The model utilized is YOLOv3, which generates low loss values and elevated mAP evaluation values through a transfer learning technique.

Figure 7: Graphical representation of different frameworks from 2005 to 2024
The evaluation’s findings show that the YOLOv3 model can distinguish between ALL and healthy cells. In previous research [116], acute lymphoblastic leukemia has been classified using Mask R-CNN on microscopic pictures of white blood cells, which can effectively and efficiently support the diagnosing process. Menagadevi et al. [117] proposed a technique that can predict ALL, they applied k-means clustering for segmentation with CNN and resulted in an accuracy of 98%, specificity of 97%, and sensitivity of 98.2%. Some of the frameworks that perform with high accuracy are given in Figs. 8–11. Although machine learning strategies present benefits regarding interpretability and reduced processing requirements, deep learning methods deliver higher precision and feature extraction abilities. A thorough evaluation of these factors like accuracy, adaptability, computational expense, and interpretability, will yield a full insight into their respective functions in the recognition and classification of ALL. Using huge dataset information, pre-trained deep learning algorithms can be fine-tuned for particular uses with small datasets [101]. This helps in medical applications with minimal labeled data.

Figure 8: Framework proposed by [99] for classification of ALL into its subtypes (Reprinted with permission from Rehman et al., Microscopy Research and Technique, 81(11): 8. Copyright 2018 by John Wiley and Sons)

Figure 9: Framework given by [121] to categorize normal and ALL blasts (Reprinted with permission from Das and Meher, Expert Systems with Applications, 183(1), Copyright 2021 by Elsevier)

Figure 10: Framework proposed by [122] to classify normal and cancerous cells

Figure 11: Framework for healthy and cancerous cells proposed by [137] (Reprinted with permission from Zakir Ullah et al., “An Attention-Based Convolutional Neural Network for Acute Lymphoblastic Leukemia Classification,” Appl. Sci., 202111(22):22. doi:10.3390/app112210662. Open Access by Creative Commons CC BY 4.0
Diverse models such as CNNs, VGGNet, and YOLO demonstrate differing efficacy contingent upon dataset size and image noise levels. Convolutional Neural Networks are versatile and can adjust to diverse tasks, although they might require greater datasets to generalize proficiently [112]. VGGNet, recognized for its deep design, performs exceptionally well with extensive, clean datasets owing to its capacity to capture complex features; yet it is prone to overfitting on smaller datasets that demand significant processing resources. YOLO, developed for real-time object recognition, excels with extensive datasets, effectively identifying things in noisy environments; nevertheless, its accuracy may diminish if the training data is not diverse [118]. In conclusion, although CNNs provide adaptability, VGGNet excels in meticulously organized settings, and YOLO, achieves a compromise, between speed and efficacy in variable contexts, rendering the selection contingent upon particular applications and data attributes. Deep learning in clinical environments where the accuracy, of data may fluctuate due to varying processing of samples or imaging conditions.
This framework [99] aims to enhance the diagnosis of Acute Lymphoblastic Leukemia (ALL) with a computer-assisted approach that integrates image processing and deep learning methodologies. The suggested method entails categorizing ALL into its subtypes and normal reactive bone marrow utilizing stained bone marrow images as shown in Fig. 8. The model was trained in bone marrow pictures using robust segmentation and deep learning with a convolutional neural network (CNN) to attain precise classification outcomes. The experimental findings demonstrated that the suggested method surpassed conventional classifiers, including Naïve Bayes, KNN, and SVM, attaining a remarkable accuracy of 97.78%. This method provides a significant resource for pathologists, improving the precision and efficacy of ALL diagnoses. Reference [121] shown in Fig. 9 introduces an effective deep Convolutional Neural Network (CNN) framework for the automated diagnosis of Acute Lymphoblastic Leukemia (ALL), tackling the issue of necessitating extensive datasets for training. The suggested approach integrates depthwise separable convolutions, linear bottleneck architecture, inverted residuals, and skip connections, in conjunction with an innovative probability-based weight factor to amalgamate MobileNetV2 and ResNet18. The methodology, corroborated on the ALLIDB1 and ALLIDB2 benchmark datasets, attains exceptional accuracy—99.39% and 97.18% for 70% training and 30% testing, and 97.92% and 96.00% for 50% training and testing. It surpasses contemporary transfer learning methodologies regarding sensitivity, specificity, accuracy, precision, F1 score, and ROC. This framework [122] for the application of Multi-Attention EfficientNetV2S and EfficientNetB3 deep learning architectures, optimized using transfer learning, to differentiate between normal and blast cells in microscopic blood smear images for the identification of acute lymphoblastic leukemia (ALL) shown in Fig. 10. The Multi-Attention Mechanism decreases model complexity and enhances generalization by altering the last blocks of both models and incorporating supplementary layers. The proposed models demonstrated exceptional accuracy, with EfficientNetV2S reaching 99.73% and EfficientNetB3 achieving 99.25%. The proposed methodology surpassed previous methods, exhibiting enhanced efficiency in leukemia identification compared to other models. Fig. 11 shows a non-invasive, CNN-based methodology for the diagnosis of Acute Lymphoblastic Leukemia (ALL) utilizing medical imaging [137]. The model integrates an Efficient Channel Attention (ECA) component with VGG16 to optimize feature extraction, hence enhancing the categorization of malignant and normal cells. The method employs data augmentation to enhance both the quality and quantity of training data, while simultaneously mitigating subject-level variability by partitioning the dataset into seven folds. The proposed model attained an accuracy of 91.1%, indicating its capability to aid pathologists in identifying ALL.
The ALL classification technique utilizing the MobileNetV2-SVM architecture proposed by Das et al. [107] attains the highest accuracy (98.21%) and the optimal F1 score (0.9828). It provides commendable performance owing to the synergistic advantages of MobileNetV2-based extraction of features and SVM-based classification. The majority of research concentrates on identifying ALL by categorizing individuals as either healthy or affected by ALL, whereas only a limited number of studies prioritize the further classification of ALL into its subtypes (L1, L2, and L3). Table 4 illustrates the classification performance of AlexNet, as proposed in [101], which categorizes white blood cells into healthy and three subtypes of acute lymphoblastic leukemia: L1, L2, and L3. L1 is identified as the most properly defined subtype within the group. The proposed approach attains an overall accuracy of 97.78%. The morphological resemblance in ALL and healthy images, the imbalanced dataset, and the existence of intersubject variability may compel a system to acquire subject-specific features instead of class-specific features [138]. Consequently, these characteristics complicate the ALL classification.

Different mathematical representation schemes to represent comparative performance are as True positive (TP) represents properly detected cells, True Negative (TN) detects normal cells, False Negative (FN) detects nonaccurate healthy cells, and False positive (FP) falsely detected affected cells. The quantitative analysis of reviewed methodologies is shown in Table 4. The comparison with existing systematic reviews is given in Table 5.
Mathematical representation is:
True negative rate or
True positive rate
Table 5 demonstrates that the majority of research is predicated on transfer learning methodologies, based on this table data, owing to their capacity to deliver favorable outcomes with limited datasets. Table 6 represents different publicly available datasets [140], in which ALLIDB1 and 2 are standard and the most popular datasets. Images examples are given in Figs. 12 and 13 while a graphical representation of the usage of datasets is given in Fig. 14. Results of different methods using these datasets were also shown graphically in Fig. 15 and ROC Curve in Fig. 16. The diversity and representativeness of datasets such as ALLIDB1, ALLIDB2, BCCD, ATLAS, and C-NMC are essential for the development of effective models for the diagnosis of acute lymphoblastic leukemia (ALL). ALLIDB1 and ALLIDB2 [141] offer images primarily related to leukemia; nevertheless, their representativeness may be constrained by the demographic and diagnostic attributes of the included individuals, thus affecting the model’s adaptability to other samples. The BCCD dataset, although useful for general blood cell evaluation, may not adequately represent the distinctive morphological characteristics of ALL cells. ATLAS provides a comprehensive framework including various blood illnesses, hence augmenting its diversity; yet it may still be deficient in comprehensive illustrations of all subtypes. C-NMC emphasizes cell morphology, essential for leukemia identification, although may not account for the heterogeneity in staining and imaging circumstances present in actual clinical environments. Therefore, although these datasets are valuable resources, their limitations in variety and representativeness must be recognized to guarantee that models trained on data can be applied effectively to diverse patients.


Figure 12: Images from the C-NMC dataset in which images A and B are normal while C and D are leukemic
Figure 13: Normal cells from (a) to (d) and ALL Blasts from (e) to (h) from the ALL-IDB dataset [141]

Figure 14: Dataset used in segmentation and classification of ALL

Figure 15: Quantitative analysis of reviewed techniques

Figure 16: ROC curve of different best-performing reviewed frameworks
The most current developments in the field are considered as this article briefly studies deep learning and conventional machine learning techniques. Classification using traditional machine learning requires additional techniques for accurately segmenting unshaped and overlapped cells by extracting features like texture, color, and geometrical features and then normalizing these using different normalization algorithms. While in deep learning all the phases mentioned above were included in a single algorithm. Deep learning models, especially convolutional neural networks (CNNs), may autonomously discern pertinent features from unprocessed data, thereby diminishing the necessity for manual feature engineering [135]. CNNs are adaptable and essential for many imaging tasks, however noise and overfitting must be managed. VGGNet might benefit via transfer learning and excels on large datasets but is highly computational and sensitive to small amounts of data without fine-tuning. In real-time object detection, YOLO works well with large datasets but may struggle with short datasets or excessive noise [108].
Although intended for real-time detection, it demands substantial resources, particularly for training on intricate datasets; yet, its architecture facilitates expedited inference, rendering it appropriate for applications where speed is paramount. The selection of a model must equilibrate performance, resource availability, and the particular requirements of the application, especially in contexts with constrained computational capability [101]. Deep learning techniques demand extensive processing resources, such as fast GPUs or TPUs, as well as plenty of RAM and storage to handle massive datasets and complicated models. Cloud computing platforms frequently offer scalable ways to satisfy these objectives effectively.
This is especially advantageous with intricate datasets, such as genetic or imaging data. However, in the deep learning approach, large-scale datasets are required to train the model efficiently and result in classification. Managing potential biases in the utilized datasets, including class imbalances, is essential for a thorough assessment of both conventional machine learning (ML) and deep learning techniques [86]. An imbalanced dataset can substantially impact the performance of models, as algorithms may exhibit bias towards the dominant class, resulting in deceptive accuracy numbers [142]. For example, if a dataset has a significant predominance of images from a certain category and a scarcity from a different one a model may attain elevated accuracy merely by identifying the majority class, but poorly generalizing to the minority class.
Deep learning algorithms, however effective in recognizing patterns from intricate data such as images, genomic, and flow cytometry data, face certain obstacles. A primary restriction is the necessity for extensive, high-quality datasets with annotations for training, which are sometimes limited, especially for rare diseases such as ALL. The models may encounter difficulties in generalizing across various patient populations or clinical environments, resulting in diminished accuracy in varied or underrepresented groups [140]. Moreover, deep learning models frequently operate as “black boxes,” complicating the interpretation of the rationale behind predictions, which is crucial in medical environments where explainability is vital for clinical decision-making. Overfitting to trained data, particularly when sample sizes are limited or unrepresentative of the larger population, can pose a considerable issue. Moreover, deep learning algorithms may exhibit sensitivity to noise and abnormalities in medical imagery or data, potentially resulting in inaccurate diagnoses [90]. A comprehensive examination of these limitations, coupled with potential solutions like data augmentation, transfer learning, and explainable AI techniques, would enhance the understanding of the challenges related to the application of deep learning in ALL diagnoses and inform future advancements in this domain [135].
To conduct a more comprehensive analysis, it is essential to examine how each study addressed class imbalance. Methods such as exceeding the minority class, reducing the majority class, or utilizing synthetic data generation techniques (such as Synthetic Minority Oversampling Technique SMOTE) help alleviate this problem. Moreover, employing performance criteria that account for class distribution, like precision, recall, F1 score, or area under the receiver’s operating characteristic curve (ROC) as shown in Fig. 16, provides a more equitable assessment of model efficacy [84]. This study will elucidate the merits and shortcomings of classical machine learning and deep learning algorithms while offering insights into the influence of dataset features on their performance, so facilitating a more comprehensive comparison.
To verify the research work done in processing medical images, different standard datasets are freely available for several types of blood diseases as mentioned in Table 4. Nowadays researchers have put some effort into analyzing data and finding new frameworks using already existing datasets and applying their methodologies using transfer learning techniques in deep learning algorithms as shown in Table 3 and show some good results, as they used already existing ideal data to investigate the issue. It is not easy to compare the accuracies using one dataset and the same algorithms. Most importantly this process needs to be verified by pathologists to save more human lives. The framework should be made with more care and use datasets having a large number of diseases. Which is one of the most difficult tasks. ALL detection and classification can face different challenges:
1. The presence of noise and inhomogeneity, weak edges, and overlapping cells can affect the results of segmentation.
2. The size, shape, and texture of cytoplasm and nucleus varies in subtypes of WBCs, so the classification task is more challenging.
3. The lack of labeled datasets prevents deep learning algorithms from performing as well as they could.
4. Very few studies have been done in terms of subclass classification of ALL to L1, L2, and L3 which is the need of the day.
5. The Overlapped cells in the slide image reduce the accuracy of the model, scientists must focus on this issue and address it.
6. Conventional and semantic segmentation of interested regions have been done in different studies, instant Segmentation should be tried in this regard.
4 Conclusion and Future Guidelines
Research work done in the field of medical images reduces the life risk of human beings. The researchers have been working in this field since 1991 till date for the diagnosis, of life-threatening diseases like leukemia and other blood-related disorders. This systematic review’s primary goal was to gather publications using PRISMA guidelines and search different databases. The primary finding of this work is that, by combining various machine learning, deep learning, and image processing using microscopic bone marrow and blood images, it is possible to detect and classify blast cells after the nucleus and cytoplasm of white blood cells have been separated. Studies have been conducted in a variety of contexts, including the categorization of leukemia into four categories, the classification of ALL and its subtypes, the identification of blasts, and the classification of leukemic and normal blood cells. Different features have been extracted like texture, color, and contour. There aren’t many benchmark datasets with uniformly sized, well-resolution images. Therefore, it is difficult to compare the suggested frameworks accurately using various tools, such as MATLAB, Google CoLab, Python, and Lab View. Most significantly, improvement in this research is urgently needed to identify the most precise and effective segmentation and classification approaches using fresh datasets for this task. A precise semantic segmentation approach that can aid in the classification of ALL and its subtypes should be proposed as part of future research efforts.
A practical finding is a possibility for transfer learning, wherein pre-trained models on extensive, well-annotated datasets can be refined for specific tasks using smaller, domain-specific datasets. This method can mitigate data shortages and enhance model performance without requiring large labeling efforts. Moreover, researchers may investigate synthetic data generation methodologies, including Generative Adversarial Networks (GANs) or data augmentation approaches, to produce a broader array of training examples. These strategies can mitigate class imbalances and improve model resilience by offering variations that replicate the real-world scenario. Moreover, engaging with domain experts for enhanced labeling methodologies, together with utilizing community-driven data annotation systems, could augment both the quality and quantity of datasets. By integrating these actionable findings, the study would provide pragmatic avenues for advancing research in this domain and improving the overall efficacy of machine learning and deep learning models. These characteristics influence their performance, facilitating a more comprehensive comparison.
Also, explainable AI is essential in detection tasks, offering knowledge about model behavior that improves reliability, conformity, and overall efficacy. As explainable artificial intelligence (XAI) approaches advance, they will assume a progressively significant role in the integration of AI into essential applications across diverse fields. Real-time diagnostic tools are transforming multiple domains by delivering instantaneous insights and improving decision-making processes. Their incorporation of sophisticated technology, including sensors, machine learning, and cloud computing, facilitates effective monitoring and diagnosis in healthcare, industrial applications, and beyond. As these systems advance, they are expected to provide enhanced advantages while tackling issues of privacy and integration.
Acknowledgement: We express our gratitude to the anonymous reviewers for their insightful comments, which greatly raised the quality of this work.
Funding Statement: This work was supported by Institute of Information & Communications Technology Planning & Evaluation (IITP) grant funded by the Korea government (MSIT) (RS-2024-00460621, Developing BCI-Based Digital Health Technologies for Mental Illness and Pain Management).
Author Contributions: The authors confirm their contribution to the paper as follows: study conception and design: Syed Ijaz Ur Rahman, Naveed Abbas; data collection: Syed Ijaz Ur Rahman; analysis and interpretation of results: Syed Ijaz Ur Rahman, Naveed Abbas, Sikandar Ali; draft manuscript preparation: Muhammad Salman, Ahmed Alkhayat, Jawad Khan, Dildar Hussain, Yeong Hyeon Gu. All authors reviewed the results and approved the final version of the manuscript.
Availability of Data and Materials: We used the benchmark online freely available datasets that are mentioned in Section 3.1 along with links.
Ethics Approval: This study did not involve human participants or animals. As such, no institutional review board (IRB) or animal ethics committee approval was required. The research was conducted following ethical guidelines relevant to the use of publicly available datasets.
Conflicts of Interest: The authors declare no conflicts of interest to report regarding the present study.
References
1. Jawahar M, Anbarasi LJ, Narayanan S, Kumar S, Ramalingam S, Venkataraman R. An attention-based deep learning for acute lymphoblastic leukemia classification. Sci Rep. 2024;14:17447. doi:10.1038/s41598-024-67826-9. [Google Scholar] [PubMed] [CrossRef]
2. Leukaemia Foundation. Acute lymphoblastic leukaemia (ALL). [cited 2024 Feb 28]. Available from: https://www.leukaemia.org.au/blood-cancer/leukaemia/acute-lymphoblastic-leukaemia/. [Google Scholar]
3. Key statistics for acute lymphocytic leukemia (ALL) [Internet]. [cited 2024 Feb 28]. Available from: https://www.cancer.org/cancer/types/acute-lymphocytic-leukemia/about/key-statistics.html. [Google Scholar]
4. Chang JHC, Poppe MM, Hua CH, Marcus KJ, Esiashvili N. Acute lymphoblastic leukemia. Pediatr Blood Cancer. 2021 May;68(Suppl 2):e28371. [Google Scholar] [PubMed]
5. Boiocchi L, Gianelli U, Iurlo A, Fend F, Bonzheim I, Cattaneo D, et al. Neutrophilic leukocytosis in advanced stage polycythemia vera: hematopathologic features and prognostic implications. Mod Pathol. 2015 Nov 1;28(11):1448–57. doi:10.1038/modpathol.2015.100. [Google Scholar] [PubMed] [CrossRef]
6. Tang G, Woods LJ, Wang SA, Brettler D, Andersen M, Miron PM, et al. Chronic basophilic leukemia: a rare form of chronic myeloproliferative neoplasm. Hum Pathol. 2009 Aug 1;40(8):1194–9. doi:10.1016/j.humpath.2009.02.011. [Google Scholar] [PubMed] [CrossRef]
7. Gupta A, Duggal R, Gehlot S, Gupta R, Mangal A, Kumar L, et al. GCTI-SN: geometry-inspired chemical and tissue invariant stain normalization of microscopic medical images. Med Image Anal. 2020 Oct 1;65:101788. doi:10.1016/j.media.2020.101788. [Google Scholar] [PubMed] [CrossRef]
8. Dhanachandra N, Manglem K, Chanu YJ. Image segmentation using K-means clustering algorithm and subtractive clustering algorithm. Procedia Comput Sci. 2015 Jan 1;54:764–71. doi:10.1016/j.procs.2015.06.090. [Google Scholar] [CrossRef]
9. Makem M, Tiedeu A. An efficient algorithm for detection of white blood cell nuclei using adaptive three stage PCA-based fusion. Inform Med Unlocked. 2020 Jan 1;20:100416. doi:10.1016/j.imu.2020.100416. [Google Scholar] [CrossRef]
10. Hassanpour H, Samadiani N, Mahdi Salehi SM. Using morphological transforms to enhance the contrast of medical images. Egypt J Radiol Nucl Med. 2015 Jun 1;46(2):481–9. doi:10.1016/j.ejrnm.2015.01.004. [Google Scholar] [CrossRef]
11. Hegde RB, Prasad K, Hebbar H, Singh BMK. Comparison of traditional image processing and deep learning approaches for classification of white blood cells in peripheral blood smear images. Biocybern Biomed Eng. 2019 Apr 1;39(2):382–92. doi:10.1016/j.bbe.2019.01.005. [Google Scholar] [CrossRef]
12. Duan Y, Wang J, Hu M, Zhou M, Li Q, Sun L, et al. Leukocyte classification based on spatial and spectral features of microscopic hyperspectral images. Opt Laser Technol. 2019 Apr 15;112:530–8. doi:10.1016/j.optlastec.2018.11.057. [Google Scholar] [CrossRef]
13. Zheng X, Wang Y, Wang G, Liu J. Fast and robust segmentation of white blood cell images by self-supervised learning. Micron. 2018 Apr 1;107(8):55–71. doi:10.1016/j.micron.2018.01.010. [Google Scholar] [PubMed] [CrossRef]
14. Anilkumar KK, Manoj VJ, Sagi TM. A survey on image segmentation of blood and bone marrow smear images with emphasis to automated detection of Leukemia. Biocybern Biomed Eng. 2020 Oct 1;40(4):1406–20. doi:10.1016/j.bbe.2020.08.010. [Google Scholar] [CrossRef]
15. Faiz M, Mounika BG, Akbar M, Srivastava S. Deep and machine learning for acute lymphoblastic leukemia diagnosis: a comprehensive review. ADCAIJ Adv Distrib Comput Artif Intell J. 2024 Jul 15;13:e31420. [Google Scholar]
16. Laosai J, Chamnongthai K. Classification of acute leukemia using medical-knowledge-based morphology and CD marker. Biomed Signal Process Control. 2018 Jul 1;44:127–37. doi:10.1016/j.bspc.2018.01.020. [Google Scholar] [CrossRef]
17. Amin J, Sharif M, Anjum M, Mussarat Y, Khattak K, Kadry S, et al. An integrated design based on dual thresholding and features optimization for white blood cells detection. IEEE Access. 2021 Oct 26;9:151421–33. doi:10.1109/ACCESS.2021.3123256. [Google Scholar] [CrossRef]
18. Khan S, Sajjad M, Abbas N, Escorcia-Gutierrez J, Gamarra M, Muhammad K. Efficient leukocytes detection and classification in microscopic blood images using convolutional neural network coupled with a dual attention network. Comput Biol Med. 2024 May 1;174:108146. doi:10.1016/j.compbiomed.2024.108146. [Google Scholar] [PubMed] [CrossRef]
19. Singhal A, Agrawal K, Quezada A, Aguiñaga A, Jiménez S, Yadav S. Explainable artificial intelligence (XAI) model for cancer image classification. Comput Model Eng Sci. 2024;141(1):401–41. doi:10.32604/cmes.2024.051363. [Google Scholar] [CrossRef]
20. Ghaderzadeh M, Asadi F, Hosseini A, Bashash D, Abolghasemi H, Roshanpour A. Machine learning in detection and classification of leukemia using smear blood images: a systematic review. Sci Program. 2021;2021(1):9933481. [Google Scholar]
21. Das PK, A DV, Meher S, Panda R, Abraham A. A systematic review on recent advancements in deep and machine learning based detection and classification of acute lymphoblastic leukemia. IEEE Access. 2022 Jan 1;10:81741–63. doi:10.1109/ACCESS.2022.3196037. [Google Scholar] [CrossRef]
22. Raina R, Gondhi NK, Gupta A. Automated segmentation of acute leukemia using blood and bone marrow smear images: a systematic review. Multimed Tools Appl. 2024 Feb 24;83;1–34. [Google Scholar]
23. Zhu C. Computational intelligence-based classification system for the diagnosis of memory impairment in psychoactive substance users. J Cloud Comput. 2024 Jun 28;13(1):119. doi:10.1186/s13677-024-00675-z. [Google Scholar] [CrossRef]
24. Moher D, Shamseer L, Clarke M, Ghersi D, Liberati A, Petticrew M, et al. Preferred reporting items for systematic review and meta-analysis protocols (PRISMA-P) 2015 statement. Syst Rev. 2015 Jan 1;4(1):1. doi:10.1186/2046-4053-4-1. [Google Scholar] [PubMed] [CrossRef]
25. Xie X, Wang X, Liang Y, Yang J, Wu Y, Li L, et al. Evaluating cancer-related biomarkers based on pathological images: a systematic review. Front Oncol. 2021 Nov 10;11:763527. doi:10.3389/fonc.2021.763527. [Google Scholar] [PubMed] [CrossRef]
26. Kulkarni-Joshi MTA, Bhosale DS. A fast segmentation scheme for acute lymphoblastic leukemia detection. Int J Adv Res Electric, Electron Instrum Energy. 2014;3:7253–8. [Google Scholar]
27. Abbas N, Mohamad D. Automatic color nuclei segmentation of leukocytes for acute leukemia. Res J Appl Sci Eng Technol. 2014 Apr 1;7:2987–93. doi:10.19026/rjaset.7.631. [Google Scholar] [CrossRef]
28. Sadeghian F, Seman Z, Ramli AR, Abdul Kahar BH, Saripan MI. A framework for white blood cell segmentation in microscopic blood images using digital image processing. Biol Proced Online. 2009 Jun 11;11:196–206. doi:10.1007/s12575-009-9011-2. [Google Scholar] [PubMed] [CrossRef]
29. Ur Rahman SI, Jadoon M, Ali S, Khattak H, Huang J. Efficient segmentation of lymphoblast in acute lymphocytic leukemia. Sci Program. 2021 May 3;2021:e7488025. [Google Scholar]
30. Cham YK, Tomari R, Wan Zakaria WN, Othman N, Safuan S, Yi J, et al. Mobile based automated complete blood count (Auto-CBC) analysis system from blood smeared image. Int J Electr Comput Eng. 2017 Dec 1;7:3020–9. [Google Scholar]
31. Scotti F. Robust segmentation and measurements techniques of white cells in blood microscope images. In: 2006 IEEE Instrumentation and Measurement Technology Conference Proceedings; 2006. p. 43–8. [Google Scholar]
32. Rezatofighi SH, Zoroofi RA, Sharifian R, Soltanian-Zadeh H. Segmentation of nucleus and cytoplasm of white blood cells using Gram-Schmidt orthogonalization and deformable models. In: 2008 9th International Conference on Signal Processing; 2008; Beijing, China. p. 801–5. doi:10.1109/ICOSP.2008.4697250. [Google Scholar] [CrossRef]
33. Rezatofighi SH, Soltanian-Zadeh H, Sharifian R, Zoroofi RA. A new approach to white blood cell nucleus segmentation based on gram-schmidt orthogonalization. In: 2009 International Conference on Digital Image Processing; 2009 Mar 7; IEEE. p. 107–11. [Google Scholar]
34. Deshpande NM, Gite S, Pradhan B, Kotecha K, Alamri A. Improved Otsu and Kapur approach for white blood cells segmentation based on LebTLBO optimization for the detection of Leukemia. Math Biosci Eng MBE. 2022 Jan;19(2):1970–2001. [Google Scholar] [PubMed]
35. Hazlyna H, Mashor M, Mokhtar N, Abdul Nasir AS, Hassan R, Raof A, et al. Comparison of acute leukemia image segmentation using HSI and RGB color space. In: 10th International Conference on Information Science, Signal Processing and their Applications (ISSPA 2010); 2010 May 10–13; Kuala Lumpur, Malaysia: IEEE. doi:10.1109/ISSPA.2010.5605410. [Google Scholar] [CrossRef]
36. Mohamed M, Far B. An enhanced threshold based technique for white blood cells nuclei automatic segmentation. In: 2012 IEEE 14th International Conference on e-Health Networking, Applications and Services (Healthcom); 2012 Oct. p. 202–7. [Google Scholar]
37. Di Ruberto C, Putzu L. Accurate blood cells segmentation through intuitionistic fuzzy set threshold. In: 10th International Conference on Signal-Image Technology and Internet-Based Systems, SITIS; 2014; Marrakech, Morocco. p. 57–64. doi:10.1109/SITIS.2014.43. [Google Scholar] [CrossRef]
38. Ahasan R, Ratul AU, Bakibillah ASM. White blood cells nucleus segmentation from microscopic images of strained peripheral blood film during leukemia and normal condition. In: 5th International Conference on Informatics, Electronics and Vision, ICIEV; 2016; Dhaka, Bangladesh. p. 361–6. doi:10.1109/ICIEV.2016.7760026. [Google Scholar] [CrossRef]
39. Lina A, Mulyawan B, Dharmawan AB. Leukocyte detection using image stitching and color overlapping windows. Int J Comput Inf Eng. 2016 Mar 2;10(5):852–7. [Google Scholar]
40. Di Ruberto C, Puztu L. White blood cells identification and counting from microscopic blood image. Int J Med Health Biomed Pharm Eng. 2013 Jan 1;7:15–22. [Google Scholar]
41. Ghosh M, Das DK, Chakraborty C, Ray A. Automated leukocyte recognition using fuzzy divergence. Micron Oxf Engl 1993. 2010 Oct 1;41:840–6. [Google Scholar]
42. Li Y, Zhu R, Mi L, Cao Y, Yao D. Segmentation of white blood cell from acute lymphoblastic leukemia images using dual-threshold method. Comput Math Methods Med. 2016 May 22;2016:e9514707. [Google Scholar]
43. Abbas N, Mohamad D, Abdullah AH, Saba T, Al-Rodhaan M, Al-Dhelaan A. Report: nuclei segmentation of leukocytes in blood smear digital images. Pak J Pharm Sci. 2015 Sep;28(5):1801–6. [Google Scholar] [PubMed]
44. Jiang K, Liao QM, Yang S. A novel white blood cell segmentation scheme using scale-space filtering and watershed clustering. Int Conf Mach Learn Cyber. 2003;5:2820. [Google Scholar]
45. Ghane N, Vard A, Talebi A, Nematollahy P. Segmentation of white blood cells from microscopic images using a novel combination of k-means clustering and modified watershed algorithm. J Med Signals Sens. 2017;7(2):92–101. doi:10.4103/2228-7477.205503. [Google Scholar] [CrossRef]
46. Liu Z, Liu J, Xiao X, Yuan H, Li X, Chang J, et al. Segmentation of white blood cells through nucleus mark watershed operations and mean shift clustering. Sensors. 2015 Sep;15(9):22561–86. doi:10.3390/s150922561. [Google Scholar] [PubMed] [CrossRef]
47. Agaian S, Madhukar M, Chronopoulos AT. Automated screening system for acute myelogenous leukemia detection in blood microscopic images. IEEE Syst J. 2014 Sep;8(3):995–1004. doi:10.1109/JSYST.4267003. [Google Scholar] [CrossRef]
48. Sajjad M, Khan S, Jan Z, Muhammad K, Moon H, Kwak JT, et al. Leukocytes classification and segmentation in microscopic blood smear: a resource-aware healthcare service in smart cities. IEEE Access. 2017;5:3475–89. doi:10.1109/Access.6287639. [Google Scholar] [CrossRef]
49. Foran DJ, Comaniciu D, Meer P, Goodell LA. Computer-assisted discrimination among malignant lymphomas and leukemia using immunophenotyping, intelligent image repositories, and telemicroscopy. IEEE Trans Inf Technol Biomed Publ IEEE Eng Med Biol Soc. 2000 Dec;4(4):265–73. doi:10.1109/4233.897058. [Google Scholar] [PubMed] [CrossRef]
50. Su J, Liu S, Song J. A segmentation method based on HMRF for the aided diagnosis of acute myeloid leukemia. Comput Methods Programs Biomed. 2017 Dec 1;152:115–23. doi:10.1016/j.cmpb.2017.09.011. [Google Scholar] [PubMed] [CrossRef]
51. Moradiamin M, Kermani S, Talebi A, Ghelich Oghli M. Recognition of acute lymphoblastic leukemia cells in microscopic images using K-means clustering and support vector machine classifier. J Med Signals Sens. 2015 Jan 3;5:49–58. doi:10.4103/2228-7477.150428. [Google Scholar] [CrossRef]
52. Liu Y, Tian J, Hu R, Yang B, Liu S, Yin L, et al. Improved feature point pair purification algorithm based on SIFT during endoscope image stitching. Front Neurorobotics. 2022 Feb 15;16:840594. doi:10.3389/fnbot.2022.840594. [Google Scholar] [PubMed] [CrossRef]
53. Gómez O, González JA, Morales EF. Image segmentation using automatic seeded region growing and instance-based learning. In: Rueda L, Mery D, Kittler J, editors. Progress in pattern recognition, image analysis and applications [Internet]. Berlin/Heidelberg: Springer Berlin Heidelberg; 2008 [cited 2024 Feb 28]. p. 192–201. Available from: http://link.springer.com/10.1007/978-3-540-76725-1_21. [Google Scholar]
54. Hazwani AHM, Mashor M, Abdul Nasir AS, Mokhtar R, Hassan R. Nucleus segmentation technique for acute leukemia. In: 2011 IEEE 7th International Colloquium on Signal Processing and its Applications; 2011; Penang, Malaysia: CSPA, p. 192–7. doi:10.1109/CSPA.2011.5759871. [Google Scholar] [CrossRef]
55. Madhloom H, Abdul Kareem S, Ariffin H. Computer-aided acute leukemia blast cells segmentation in peripheral blood images. J Vibroengineering. 2015 Dec 1;17:4517–32. [Google Scholar]
56. Gim JW, Park J, Lee JH, Ko B, Nam JY. A novel framework for white blood cell segmentation based on stepwise rules and morphological features. In: Image processing: machine vision applications IV; 2011 Feb 7; SPIE. Vol. 7877. p. 132–8. [Google Scholar]
57. Theera-Umpon N, Dhompongsa S. Morphological granulometric features of nucleus in automatic bone marrow white blood cell classification. IEEE Trans Inf Technol Biomed Publ IEEE Eng Med Biol Soc. 2007 May;11:353–9. doi:10.1109/TITB.2007.892694. [Google Scholar] [PubMed] [CrossRef]
58. Piuri V, Scotti F. Morphological classification of blood leucocytes by microscope images. In: 2004 IEEE International Conference on Computational Intelligence for Measurement Systems and Applications, 2004 CIMSA; 2004; Boston, MA, USA: IEEE. p. 103–8. doi:10.1109/CIMSA.2004.1397242. [Google Scholar] [CrossRef]
59. Scotti F. Automatic morphological analysis for acute leukemia identification in peripheral blood microscope images. In: CIMSA 2005 IEEE International Conference on Computational Intelligence for Measurement Systems and Applications; 2005 Jul 20; IEEE. p. 96–101. [Google Scholar]
60. Vogado LHS, Veras RDMS, Andrade AR, Silva RRVE, De Araujo FHD, De Medeiros FNS. Unsupervised leukemia cells segmentation based on multi-space color channels. In: 2016 IEEE International Symposium on Multimedia; 2016 Dec. p. 451–6. [Google Scholar]
61. Bhattacharjee R, Saini LM. Robust technique for the detection of acute lymphoblastic leukemia. In: 2015 IEEE Power, Communication and Information Technology Conference (PCITC); 2015 Oct 15; IEEE. p. 657–62. [Google Scholar]
62. Grimwade LF, Fuller KA, Erber WN. Applications of imaging flow cytometry in the diagnostic assessment of acute leukaemia. Methods San Diego Calif. 2017 Jan 1;112:39–45. doi:10.1016/j.ymeth.2016.06.023. [Google Scholar] [PubMed] [CrossRef]
63. Bhukya EA. Detection of acute lymphoblastic leukemia using microscopic images of blood. Int J Adv Appl Sci. 2017 Aug;4(8):74–8. doi:10.21833/ijaas.2017.08.011. [Google Scholar] [CrossRef]
64. Nee LH, Mashor MY, Hassan R. White blood cell segmentation for acute leukemia bone marrow images. J Med Imaging Health Informat. 2012 Sep 1;2(3):278–84. doi:10.1166/jmihi.2012.1099. [Google Scholar] [CrossRef]
65. Dorini LB, Minetto R, Leite NJ. White blood cell segmentation using morphological operators and scale-space analysis. In: XX Brazilian Symposium on Computer Graphics and Image Processing; 2007 Oct. p. 294–304. [Google Scholar]
66. Abdulla AA. Efficient computer-aided diagnosis technique for leukaemia cancer detection. IET Image Process. 2020;14(17):4435–40. doi:10.1049/iet-ipr.2020.0978. [Google Scholar] [CrossRef]
67. Mohammed ZF, Abdulla AA. An efficient CAD system for ALL cell identification from microscopic blood images. Multimed Tools Appl. 2021 Feb 1;80(4):6355–68. doi:10.1007/s11042-020-10066-6. [Google Scholar] [CrossRef]
68. Chin Neoh S, Srisukkham W, Zhang L, Todryk S, Greystoke B, Peng Lim C, et al. An intelligent decision support system for leukaemia diagnosis using microscopic blood images. Sci Rep. 2015 Oct 9;5(1):14938. doi:10.1038/srep14938. [Google Scholar] [PubMed] [CrossRef]
69. Al-jaboriy SS, Sjarif NNA, Chuprat S, Abduallah WM. Acute lymphoblastic leukemia segmentation using local pixel information. Pattern Recognit Lett. 2019 Jul 1;125:85–90. doi:10.1016/j.patrec.2019.03.024. [Google Scholar] [CrossRef]
70. Wang Y, Cao Y. Quick leukocyte nucleus segmentation in leukocyte counting. Comput Math Methods Med. 2019;2019:3072498. doi:10.1155/2019/3072498. [Google Scholar] [PubMed] [CrossRef]
71. Zhang C, Wu S, Lu Z, Shen Y, Wang J, Huang P, et al. Hybrid adversarial-discriminative network for leukocyte classification in leukemia. Med Phys. 2020 Aug;47(8):3732–44. doi:10.1002/mp.v47.8. [Google Scholar] [CrossRef]
72. Wang Q, Bi S, Sun M, Wang Y, Wang D, Yang S. Deep learning approach to peripheral leukocyte recognition. PLoS One. 2019 Jun 25;14(6):e0218808. doi:10.1371/journal.pone.0218808. [Google Scholar] [PubMed] [CrossRef]
73. Liu W, Anguelov D, Erhan D, Szegedy C, Reed S, Fu CY, et al. SSDb: single shot multibox detector; 2016 [cited 2024 Feb 28]. p. 21–37. Available from: http://arxiv.org/abs/1512.02325. [Google Scholar]
74. Mandal S, Daivajna V, Kalsangra S, Rajagopalan V, Kuchlous A. Computer aided system for automatic detection and marking instance of nuclei. In: 2019 IEEE International Conference on Electrical, Computer and Communication Technologies (ICECCT); 2019 Feb 20; IEEE. p. 1–6. [Google Scholar]
75. Shahin AI, Guo Y, Amin KM, Sharawi AA. White blood cells identification system based on convolutional deep neural learning networks. Comput Methods Programs Biomed. 2019 Jan;168:69–80. doi:10.1016/j.cmpb.2017.11.015. [Google Scholar] [PubMed] [CrossRef]
76. Saleem S, Amin J, Sharif M, Mallah GA, Kadry S, Gandomi AH. Leukemia segmentation and classification: a comprehensive survey. Comput Biol Med. 2022 Nov 1;150:106028. doi:10.1016/j.compbiomed.2022.106028. [Google Scholar] [PubMed] [CrossRef]
77. Duggal R, Gupta A, Gupta R, Wadhwa M, Ahuja C. Overlapping cell nuclei segmentation in microscopic images using deep belief networks. In: Proceedings of the Tenth Indian Conference on Computer Vision, Graphics and Image Processing; 2016; Guwahati, Assam, India: ACM. p. 1–8. doi:10.1145/3009977.3010043. [Google Scholar] [CrossRef]
78. Reena MR, Ameer PM. Localization and recognition of leukocytes in peripheral blood: a deep learning approach. Comput Biol Med. 2020 Nov;126:104034. doi:10.1016/j.compbiomed.2020.104034. [Google Scholar] [PubMed] [CrossRef]
79. Gokulkannan K, Mohanaprakash TA, DafniRose J, Sriman B. Multiscale adaptive and attention-dilated convolutional neural network for efficient leukemia detection model with multiscale trans-res-Unet3+ -based segmentation network. Biomed Signal Process Control. 2024 Apr 1;90:105847. doi:10.1016/j.bspc.2023.105847. [Google Scholar] [CrossRef]
80. Amin J, Anjum MA, Krivic S, Sharif MI. Segmentation and classification of lymphoblastic leukaemia using quantum neural network. Expert Syst. 2022 Dec 23:e13225. [Google Scholar]
81. Al-Zubaidi AS, Al-Mukhtar M, Baghdadi AAA. ALL-FABNET: acute lymphocytic leukemia segmentation using a flipping attention block decoder-encoder network. J Image Graph. 2024;12(3):239–49. doi:10.18178/joig. [Google Scholar] [CrossRef]
82. Ko B, Gim JW, Nam JY. Cell image classification based on ensemble features and random forest. Electron Lett. 2011 Jun 26;47:638–9. doi:10.1049/el.2011.0831. [Google Scholar] [CrossRef]
83. Ramoser H, Laurain V, Bischof H, Ecker R. Leukocyte segmentation and classification in blood-smear images. In: 2005 IEEE Engineering in Medicine and Biology 27th Annual Conference; 2006 Jan 17; IEEE. p. 3371–4. [Google Scholar]
84. Dese K, Raj H, Ayana G, Yemane T, Adissu W, Krishnamoorthy J, et al. Accurate machine-learning-based classification of leukemia from blood smear images. Clin Lymphoma Myeloma Leuk. 2021 Nov;21(11):e903–14. doi:10.1016/j.clml.2021.06.025. [Google Scholar] [PubMed] [CrossRef]
85. Dharani T, Hariprasath S. Diagnosis of leukemia and its types using digital image processing techniques. In: 2018 3rd International Conference on Communication and Electronics systems (ICCES); 2018 Oct 15; IEEE. p. 275–9. [Google Scholar]
86. Tai WL, Hu RM, Hsiao HC, Chen RM, Tsai JJ. Blood cell image classification based on hierarchical SVM. In: 2011 IEEE International Symposium on Multimedia; 2011 Dec 5; IEEE. p. 129–36. [Google Scholar]
87. Mohapatra S, Patra D. Automated cell nucleus segmentation and acute leukemia detection in blood microscopic images. In: 2010 International Conference on Systems in Medicine and Biology; 2010 Dec 16; IEEE. p. 49–54. [Google Scholar]
88. Rawat J, Singh A, Bhadauria H, Virmani J. Computer aided diagnostic system for detection of leukemia using microscopic images. Procedia Comput Sci. 2015 Dec 31;70:748–56. doi:10.1016/j.procs.2015.10.113. [Google Scholar] [CrossRef]
89. Mishra S, Majhi B, Sa PK, Sharma L. Gray level co-occurrence matrix and random forest based acute lymphoblastic leukemia detection. Biomed Signal Process Control. 2017 Mar 1;33:272–80. doi:10.1016/j.bspc.2016.11.021. [Google Scholar] [CrossRef]
90. MoradiAmin M, Memari A, Samadzadehaghdam N, Kermani S, Talebi A. Computer aided detection and classification of acute lymphoblastic leukemia cell subtypes based on microscopic image analysis. Microsc Res Tech. 2016 Oct;79(10):908–16. doi:10.1002/jemt.22718. [Google Scholar] [PubMed] [CrossRef]
91. Pan C, Lu H, Cao F. Segmentation of blood and bone marrow cell images via learning by sampling. In: Huang DS, Jo KH, Lee HH, Kang HJ, Bevilacqua V, editors. Emerging intelligent computing technology and applications [Internet]. Berlin/Heidelberg: Springer Berlin Heidelberg; 2009 [cited 2024 Feb 28]. p. 336–45. Available from: http://link.springer.com/10.1007/978-3-642-04070-2_38. [Google Scholar]
92. Mohapatra S, Patra D, Satpathi S. Unsupervised blood microscopic image segmentation and leukemia detection using color based clustering. Int J Comput Inf Syst Ind Manag Appl. 2012 Jan 1;4:477–85. [Google Scholar]
93. Automated acute myelogenous lukemia detection in blood microscopic image. Int J Sci Res. 2015 Dec 5;4(12):1136–9. [Google Scholar]
94. Asadi MR, Vahedi A, Amindavar H. Leukemia cell recognition with Zernike moments of holographic images. In: Proceedings of the 7th Nordic Signal Processing Symposium-NORSIG 2006; 2006 Jun 7; IEEE. p. 214–7. [Google Scholar]
95. Abdeldaim AM, Sahlol AT, Elhoseny M, Hassanien AE. Computer-aided acute lymphoblastic leukemia diagnosis system based on image analysis. In: Hassanien A, Oliva D, editors, Advances in soft computing and machine learning in image processing. Studies in computational intelligence. Springer, Cham. Vol. 730, p. 131–47. doi:10.1007/978-3-319-63754-9_7. [Google Scholar] [CrossRef]
96. Moshavash Z, Danyali H, Helfroush MS. An automatic and robust decision support system for accurate acute leukemia diagnosis from blood microscopic images. J Digit Imaging. 2018 Oct;31(5):702–17. doi:10.1007/s10278-018-0074-y. [Google Scholar] [PubMed] [CrossRef]
97. Di Ruberto C, Loddo A, Putzu L. A multiple classifier learning by sampling system for white blood cells segmentation. In: Computer Analysis of Images and Patterns: 16th International Conference; 2015 Sep 2–4; Valletta, Malta: Springer International Publishing. p. 415–25. [Google Scholar]
98. Sahlol AT, Kollmannsberger P, Ewees AA. Efficient classification of white blood cell leukemia with improved swarm optimization of deep features. Sci Rep. 2020 Feb 13;10:2536. doi:10.1038/s41598-020-59215-9. [Google Scholar] [PubMed] [CrossRef]
99. Rehman A, Abbas N, Saba T, Rahman SIU, Mehmood Z, Kolivand H. Classification of acute lymphoblastic leukemia using deep learning. Microsc Res Tech. 2018;81(11):1310–7. doi:10.1002/jemt.23139. [Google Scholar] [PubMed] [CrossRef]
100. Shafique S, Tehsin S. Acute lymphoblastic leukemia detection and classification of its subtypes using pretrained deep convolutional neural networks. Technol Cancer Res Treat. 2018 Jan 1;17:1533033818802789. doi:10.1177/1533033818802789. [Google Scholar] [PubMed] [CrossRef]
101. Loey M, Naman M, Zayed H. Deep transfer learning in diagnosing leukemia in blood cells. Computers. 2020 Jun 9;9(2):29. doi:10.3390/computers9020029. [Google Scholar] [CrossRef]
102. Mallick PK, Mohapatra SK, Chae GS, Mohanty MN. Convergent learning-based model for leukemia classification from gene expression. Pers Ubiquitous Comput. 2023 Jun 1;27(3):1103–10. doi:10.1007/s00779-020-01467-3. [Google Scholar] [PubMed] [CrossRef]
103. Genovese A. ALLNet: Acute lymphoblastic leukemia detection using lightweight convolutional networks. In: 2022 IEEE 9th International Conference on Computational Intelligence and Virtual Environments for Measurement Systems and Applications (CIVEMSA); 2022 Jun 15; IEEE. p. 1–6. [Google Scholar]
104. Wang X, Ou C, Hu Z, Ge A, Wang Y, Cao K. Cell nuclear segmentation of B-ALL images based on MSFF-SegNeXt. J Multidiscip Healthc. 2024 Dec 31;17:5675–93. doi:10.2147/JMDH.S492655. [Google Scholar] [PubMed] [CrossRef]
105. Berezsky O, Liashchynskyi P, Pitsun O, Izonin I. Synthesis of convolutional neural network architectures for biomedical image classification. Biomed Signal Process Control. 2024 Sep 1;95:106325. doi:10.1016/j.bspc.2024.106325. [Google Scholar] [CrossRef]
106. Houssein EH, Emam MM, Ali AA, Suganthan PN. Deep and machine learning techniques for medical imaging-based breast cancer: a comprehensive review. Expert Syst Appl. 2021 Apr 1;167:114161. doi:10.1016/j.eswa.2020.114161. [Google Scholar] [CrossRef]
107. Yin L, Wang L, Lu S, Wang R, Yang Y, Yang B, et al. Convolution-transformer for image feature extraction. Comput Model Eng Sci. 2024;141(1):87–106. doi:10.32604/cmes.2024.051083. [Google Scholar] [CrossRef]
108. Redmon J, Farhadi A. YOLOv3: an incremental improvement [Internet]; 2018 Apr 8 [cited 2024 Feb 28]. Available from:https://www.semanticscholar.org/paper/YOLOv3%3A-An-Incremental-Improvement-Redmon-Farhadi/ebc96892b9bcbf007be9a1d7844e4b09fde9d961. [Google Scholar]
109. Bochkovskiy A, Wang CY, Liao H. YOLOv4: optimal speed and accuracy of object detection [Internet]; 2020 Apr 23 [cited 2024 Feb 28]. Available from:https://www.semanticscholar.org/paper/YOLOv4%3A-Optimal-Speed-and-Accuracy-of-Object-Bochkovskiy-Wang/2a6f7f0d659c5f7dcd665064b71e7b751592c80e. [Google Scholar]
110. Al-Qudah R, Suen CY. Synthetic blood smears generation using locality sensitive hashing and deep neural networks. IEEE Access. 2020;8:102530–9. doi:10.1109/Access.6287639. [Google Scholar] [CrossRef]
111. Redmon J, Farhadi A. YOLO9000: better, faster, stronger. In: Proceedings of the IEEE conference on Computer Vision and Pattern Recognition; 2017. p. 7263–71. [Google Scholar]
112. Khandekar R, Shastry P, Jaishankar S, Faust O, Sampathila N. Automated blast cell detection for Acute Lymphoblastic Leukemia diagnosis. Biomed Signal Process Control. 2021 Jul;68:102690. doi:10.1016/j.bspc.2021.102690. [Google Scholar] [CrossRef]
113. Duggal R, Gupta A, Gupta R, Mallick P. SD-Layer: stain deconvolutional layer for CNNs in medical microscopic imaging. In: Descoteaux M, Maier-Hein L, Franz A, Jannin P, Collins DL, Duchesne S, editors. Cham: Springer International Publishing; 2017 [cited 2024 Feb 28]. p. 435–43. Available from: https://link.springer.com/10.1007/978-3-319-66179-7_50. [Google Scholar]
114. Sulaiman A, Kaur S, Gupta S, Alshahrani H, Reshan MSA, Alyami S, et al. ResRandSVM: hybrid approach for acute lymphocytic leukemia classification in blood smear images. Diagn Basel Switz. 2023 Jun 20;13(12):2121. [Google Scholar]
115. Magpantay LD, Alon HD, Austria YD, Melegrito MP, Fernando GJ. A transfer learning-based deep CNN approach for classification and diagnosis of acute lymphocytic leukemia cells. In: 2022 International Conference on Decision Aid Sciences and Applications (DASA); 2022 Mar 23; IEEE. p. 280–4. [Google Scholar]
116. Revanda AR, Fatichah C, Suciati N. Classification of acute lymphoblastic leukemia on white blood cell microscopy images based on instance segmentation using mask R-CNN. Int J Intell Eng Syst. 2022 Oct 31;15(5):625–37. [Google Scholar]
117. Menagadevi M, Nirmala M, Thiyagarajan D, Rajkumar R. Web-based approach for detection of acute Lymphoblastic Leukemia from microscopic blood cell images using convolutional neural network. 2023. doi:10.21203/rs.3.rs-2673034/v1. [Google Scholar] [CrossRef]
118. Banik PP, Saha R, Kim KD. An automatic nucleus segmentation and CNN model based classification method of white blood cell. Expert Syst Appl. 2020 Jul;149:113211. doi:10.1016/j.eswa.2020.113211. [Google Scholar] [CrossRef]
119. Claro M, Vogado L, Veras R, Santana A, Tavares J, Santos J, et al. Convolution neural network models for acute leukemia diagnosis. In: 2020 International Conference on Systems, Signals and Image Processing (IWSSIP); 2020 Jul 1; IEEE. p. 63–8. [Google Scholar]
120. Sriram G, Babu TRG, Praveena R, Anand JV. Classification of leukemia and leukemoid using VGG-16 convolutional neural network architecture. Mol Cell Biomech. 2022 Jan 1;19:29–40. doi:10.32604/mcb.2022.016966. [Google Scholar] [CrossRef]
121. Das PK, Meher S. An efficient deep convolutional neural network based detection and classification of acute lymphoblastic leukemia. Expert Syst Appl. 2021 Nov;183:115311. doi:10.1016/j.eswa.2021.115311. [Google Scholar] [CrossRef]
122. Saeed A, Shoukat S, Shehzad K, Ahmad I, Eshmawi AA, Amin AH, et al. A deep learning-based approach for the diagnosis of acute lymphoblastic leukemia. Electronics. 2022 Jan;11(19):3168. doi:10.3390/electronics11193168. [Google Scholar] [CrossRef]
123. Abunadi I, Senan EM. Multi-method diagnosis of blood microscopic sample for early detection of acute lymphoblastic leukemia based on deep learning and hybrid techniques. Sensors. 2022 Jan;22(4):1629. doi:10.3390/s22041629. [Google Scholar] [PubMed] [CrossRef]
124. Sampathila N, Chadaga K, Goswami N, Chadaga RP, Pandya M, Prabhu S, et al. Customized deep learning classifier for detection of acute lymphoblastic leukemia using blood smear images. Healthcare. 2022 Oct;10(10):1812. doi:10.3390/healthcare10101812. [Google Scholar] [PubMed] [CrossRef]
125. Boldú L, Merino A, Acevedo A, Molina A, Rodellar J. A deep learning model (ALNet) for the diagnosis of acute leukaemia lineage using peripheral blood cell images. Comput Methods Programs Biomed. 2021 Apr;202:105999. doi:10.1016/j.cmpb.2021.105999. [Google Scholar] [PubMed] [CrossRef]
126. Chen YM, Chou FI, Ho WH, Tsai JT. Classifying microscopic images as acute lymphoblastic leukemia by Resnet ensemble model and Taguchi method. BMC Bioinformatics. 2022 Jan 11;22(5):615. [Google Scholar]
127. Kasani PH, Park SW, Jang JW. An aggregated-based deep learning method for leukemic b-lymphoblast classification. Diagn Basel Switz. 2020 Dec 8;10(12):1064. [Google Scholar]
128. Atteia G, Alhussan AA, Samee NA. BO-ALLCNN: bayesian-based optimized CNN for acute lymphoblastic leukemia detection in microscopic blood smear images. Sensors. 2022 Jul 24;22(15):5520. doi:10.3390/s22155520. [Google Scholar] [PubMed] [CrossRef]
129. Syed SA, Nisar H, Jaffari R, Hum YC, Jen LY, Qaisar SM. Enhancing leukemia detection: an automated approach using deep learning and ensemble techniques [Internet]; 2024 [cited 2024 Feb 28]. Rochester, NY, USA. Available from: https://papers.ssrn.com/abstract=4689419. [Google Scholar]
130. Anwar S, Alam A. A convolutional neural network-based learning approach to acute lymphoblastic leukaemia detection with automated feature extraction. Med Biol Eng Comput. 2020 Dec;58(12):3113–21. doi:10.1007/s11517-020-02282-x. [Google Scholar] [PubMed] [CrossRef]
131. Alagu S, N. AP, K. BB. Automatic detection of acute lymphoblastic leukemia using UNET based segmentation and statistical analysis of fused deep features. Appl Artif Intell. 2021 Dec 15;35(15):1952–69. doi:10.1080/08839514.2021.1995974. [Google Scholar] [CrossRef]
132. Sneha D, Alagu S. Chronological sine cosine algorithm based deep CNN for acute lymphocytic leukemia detection. In: Artificial Intelligence: Advances and Application (ICAIAA 2021). 2021 [cited 2024 Feb 28]. Available from: https://www.researchgate.net/publication/353659892. [Google Scholar]
133. Jha KK, Dutta HS. Mutual information based hybrid model and deep learning for Acute Lymphocytic Leukemia detection in single cell blood smear images. Comput Methods Programs Biomed. 2019 Oct;179:104987. doi:10.1016/j.cmpb.2019.104987. [Google Scholar] [PubMed] [CrossRef]
134. Kumar I, Bhatt C, Vimal V, Qamar S. Automated white corpuscles nucleus segmentation using deep neural network from microscopic blood smear. J Intell Fuzzy Syst. 2021 Mar 15;42:1–14. [Google Scholar]
135. Agughasi V, Murali S. i-Net: a deep CNN model for white blood cancer segmentation and classification. Int J Adv Technol Eng Explor. 2022 Oct 31;9:1448–64. [Google Scholar]
136. Boreiri Z, Azad AN, Ghodousian A. A convolutional neuro-fuzzy network using fuzzy image segmentation for acute leukemia classification. In: 2022 27th International Computer Conference, Computer Society of Iran (CSICC); 2022 Feb 23; IEEE. p. 1–7. [Google Scholar]
137. Zakir Ullah M, Zheng Y, Song J, Aslam S, Xu C, Kiazolu GD, et al. An attention-based convolutional neural network for acute lymphoblastic leukemia classification. Appl Sci. 2021 Jan;11(22):10662. doi:10.3390/app112210662. [Google Scholar] [CrossRef]
138. Goswami S, Mehta S, Sahrawat D, Gupta A, Gupta R. Heterogeneity loss to handle intersubject and intrasubject variability in cancer. 2020 Mar 19. doi:10.48550/arXiv.2003.03295.141. [Google Scholar] [CrossRef]
139. Mustaqim T, Fatichah C, Suciati N. Deep learning for the detection of acute lymphoblastic leukemia subtypes on microscopic images: a systematic literature review. IEEE Access. 2023;11:16108–27. doi:10.1109/ACCESS.2023.3245128. [Google Scholar] [CrossRef]
140. Su J, Han J, Song J. A benchmark bone marrow aspirate smear dataset and a multi-scale cell detection model for the diagnosis of hematological disorders. Comput Med Imaging Graph J Comput Med Imaging Soc. 2021 Jun;90:101912. doi:10.1016/j.compmedimag.2021.101912. [Google Scholar] [PubMed] [CrossRef]
141. Labati RD, Piuri V, Scotti F. All-IDB: the acute lymphoblastic leukemia image database for image processing; 2011; Brussels, Belgium. p. 2045–8. doi:10.1109/ICIP.2011.6115881. [Google Scholar] [CrossRef]
142. Genovese A, Piuri V, Plataniotis KN, Scotti F. DL4ALL: multi-task cross-dataset transfer learning for acute lymphoblastic leukemia detection. IEEE Access. 2023;11:65222–37. doi:10.1109/ACCESS.2023.3289219. [Google Scholar] [CrossRef]
Cite This Article
Copyright © 2025 The Author(s). Published by Tech Science Press.This work is licensed under a Creative Commons Attribution 4.0 International License , which permits unrestricted use, distribution, and reproduction in any medium, provided the original work is properly cited.


Submit a Paper
Propose a Special lssue
View Full Text
Download PDF


Downloads
Citation Tools